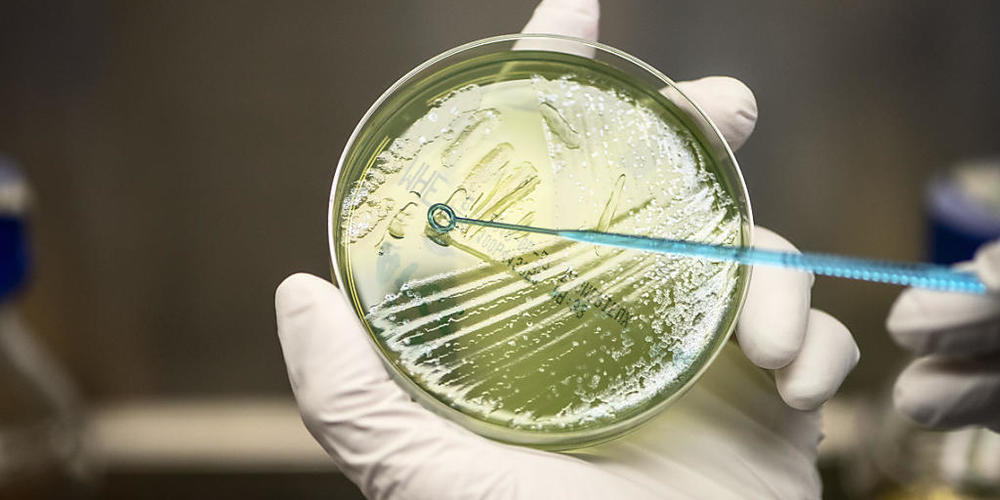
Betrifft auch die Schweiz: Die EU-Wissenschaftsminister diskutieren am Dienstag in Brüssel über die neuen Assoziierungsregeln für Drittstaaten an das EU-Forschungsprogramm Horizon Europe (2021-2027).

Die EU-Kommission hatte bei ihrem Vorschlag zum EU-Forschungsprogramm eine neue, strengere Kategorisierung bei der Assoziierung von Drittstaaten vorgenommen. Eine Rolle für diese Neuordnung dürfte vor allem der Brexit spielen.
Doch das hat auch Konsequenzen für die Schweiz: Während sie bis anhin gleich behandelt wurde wie die EFTA/EWR-Staaten Norwegen, Island und Liechtenstein, fand sich die Schweiz neu in der vierten, der letzten Kategorie wieder.
In der Schweizer Forschung befürchtet man, dass mit dieser Degradierung die Teilnahme an "Horizon Europe" in gewissen Teilen eingeschränkt oder an zusätzliche Bedingungen geknüpft werden könnte. Seitens der EU heisst es hingegen, sämtliche Details müssten zwischen der Schweiz und der EU ausgehandelt werden. Das neue Forschungsprogramm startet im Januar 2021.